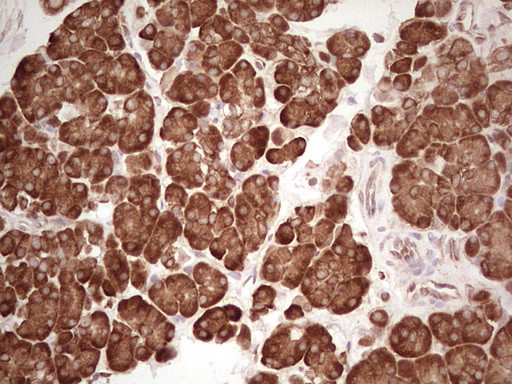
WIBG Antibody in Immunohistochemistry (Paraffin) (IHC (P))

Search
OriGene
WIBG Monoclonal Antibody (OTI2C1), TrueMAB™
{{$productOrderCtrl.translations['antibody.pdp.commerceCard.promotion.promotions']}}
{{$productOrderCtrl.translations['antibody.pdp.commerceCard.promotion.viewpromo']}}
{{$productOrderCtrl.translations['antibody.pdp.commerceCard.promotion.promocode']}}: {{promo.promoCode}} {{promo.promoTitle}} {{promo.promoDescription}}. {{$productOrderCtrl.translations['antibody.pdp.commerceCard.promotion.learnmore']}}
产品信息
TA806605
种属反应
宿主/亚型
分类
类型
克隆号
抗原
偶联物
形式
浓度
纯化类型
保存液
内含物
保存条件
运输条件
靶标信息
Key regulator of the exon junction complex (EJC), a multiprotein complex that associates immediately upstream of the exon-exon junction on mRNAs and serves as a positional landmark for the intron exon structure of genes and directs post-transcriptional processes in the cytoplasm such as mRNA export, nonsense-mediated mRNA decay (NMD) or translation. Acts as an EJC disassembly factor, allowing translation-dependent EJC removal and recycling by disrupting mature EJC from spliced mRNAs. Its association with the 40S ribosomal subunit probably prevents a translation-independent disassembly of the EJC from spliced mRNAs, by restricting its activity to mRNAs that have been translated. Interferes with NMD and enhances translation of spliced mRNAs, probably by antagonizing EJC functions. May bind RNA; the relevance of RNA-binding remains unclear in vivo, RNA-binding was detected by PubMed:14968132, while PubMed:19410547 did not detect RNA-binding activity independently of the EJC. [UniProt]
仅用于科研。不用于诊断过程。未经明确授权不得转售。
篇参考文献 (0)
生物信息学
蛋白别名: Partner of Y14 and mago; Protein wibg homolog; PYM homolog 1 exon junction complex-associated factor; within bgcn homolog
基因别名: PYM; PYM1; WIBG
UniProt ID: (Human) Q9BRP8
Entrez Gene ID: (Human) 84305